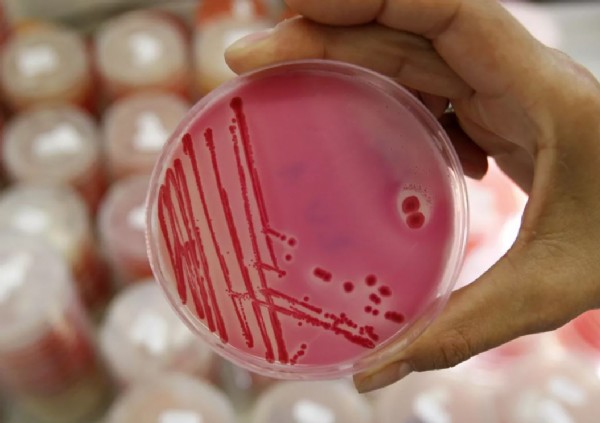
ABD'de salgın paniği! Hastaneler doldu!

ABD'de salgın paniği! Hastaneler doldu!
ABD'de kuru soğandan kaynaklanan salmonella salgınında 650 kişinin hastalandığı açıklandı.

Salgının Meksika'nın Chihuahua şehrinden ağustosta ithal edilen beyaz ve kırmızı soğanlardan kaynaklandığı tespit edildi.
Salmonella, tifo, paratifo ve gıda zehirlenmesine yol açabilen, çubuksu, Gram-negatif bir enterobakteri cinsi olarak biliniyor.
Söz konusu türler, hareketli olmasının yanında, insan vücudunda hidrojen sülfür üretiyor.